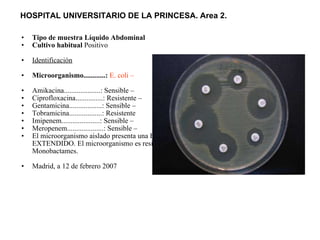
Tipo de muestra Líquido Abdominal Cultivo habitual  Positivo  Identificación   Microorganismo............:   E. coli –   Amikacina....................: Sensible –  Ciprofloxacina...............: Resistente –  Gentamicina..................: Sensible –  Tobramicina..................: Resistente  Imipenem.....................: Sensible –  Meropenem....................: Sensible –  El microorganismo aislado presenta una BETA- LACTAMASA DE ESPECTRO EXTENDIDO. El microorganismo es resistente a todas las Penicilinas, Cefalosporinas y Monobactames.  Madrid, a 12 de febrero 2007  HOSPITAL UNIVERSITARIO DE LA PRINCESA. Area 2.

El documento discute los principios del tratamiento antibiótico empírico inicial en pacientes graves. Enfatiza la importancia de acertar el tratamiento desde el principio, teniendo en cuenta aspectos como la farmacodinámica y la duración adecuada del tratamiento. También resalta la necesidad de optimizar la administración de antibióticos para mejorar los resultados clínicos y reducir la aparición de resistencias.